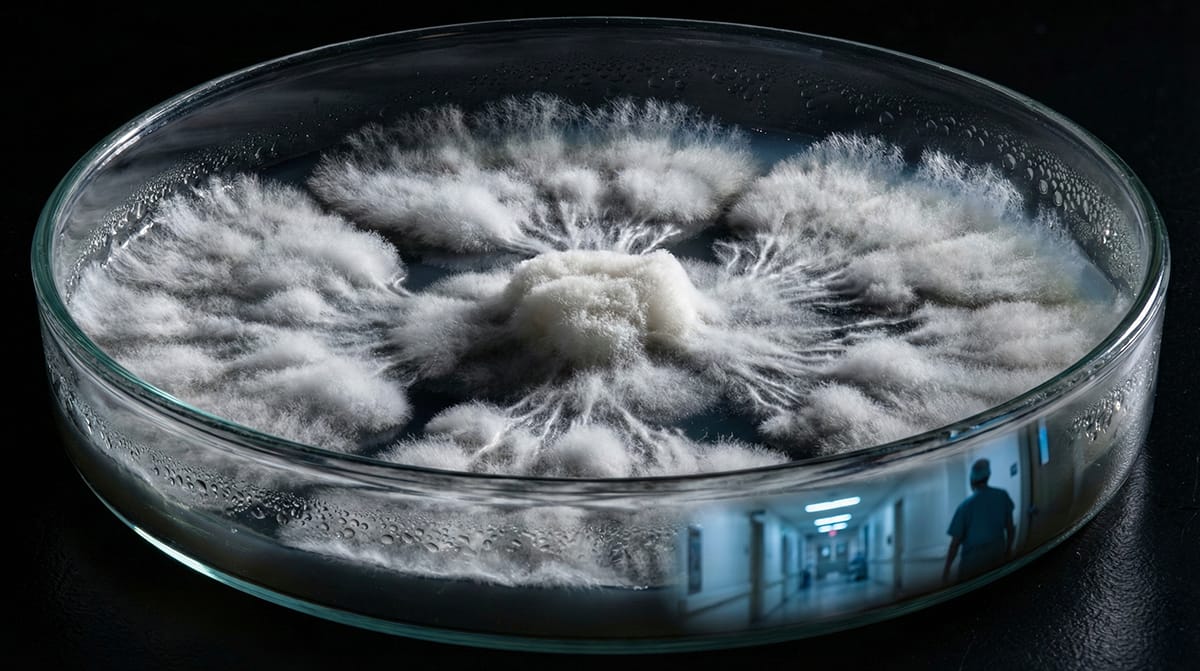

- Vejon MED
- Posts
- Fungal Horror in the Brain:
Fungal Horror in the Brain:
The Coccidioidomycosis Infection That Exposed a Hidden Immune Crisis

A Message from Dr. McMillan
One of the ongoing challenges within the clinical community is that, politically, COVID has been declared “over.” Yet in practice, many clinicians are still encountering presentations that strongly suggest otherwise.
When real-world clinical patterns continue to point toward significant disease, it becomes our responsibility to look beyond prevailing narratives and ask harder questions. Ignoring these signals does not serve patients, and it does not serve medicine.
This is a call for clinicians to think more broadly, to question assumptions, and to remain intellectually courageous. Now more than ever, patients need doctors who are willing to step outside the box and pursue understanding - rather than accept closure where none truly exists.
Dr. Philip McMillan
In this week's January 23rd, 2026 update:
Covid-19: Fungal infection and immune crisis
Vejon: This week’s featured Vejon video
Health: The pandemic’s hidden toll
Infographic: Fungal horror in the brain
News: Medical news in brief
Education: Heal yourself. Help others. Learn the ROOT approach
Read time: 6 minutes
FEATURE ARTICLE
COVID-19
Fungal Horror in the Brain: The Coccidioidomycosis Infection That Exposed a Hidden Immune Crisis
Authors: Dr. Philp McMillan, John McMillan
A BMJ case report describes a 70-year-old California man with a rare fungal brain infection whose lung scans showed COVID-19 hallmarks, yet he was never tested for COVID.
The patient's immune dysregulation pattern - lymphopenia, depleted B cells, and diminished NK cells - is consistent with post-COVID immune damage.
Researchers suggest a "subclinical cytokine storm" from undiagnosed COVID may have created the functional immunodeficiency that allowed fungal spread.
The case highlights a potential dangerous diagnostic blind spot: clinicians may miss COVID-induced immune dysfunction driving unusual infections.
Why this is important: Undiagnosed COVID-19 may be silently damaging immune systems, leaving patients vulnerable to rare and dangerous infections. When a fungal infection spread to one man's brain despite no apparent immune disorder, the culprit may have been COVID for which he was not tested. Doctors need to recognize this hidden pattern.
SUPPORT VEJON MED
SUPPORT education in science and medicine. Your ONE-TIME donation will help us maintain our independence, compensate our dedicated team, and continue delivering high-quality content free from industry influence.
HEALTH
The Pandemic’s Hidden Toll: Millions of Chronic Conditions Left Undiagnosed
Author: Mark Russell, King’s College London
COVID-19 pandemic disrupted healthcare systems, causing sharp drops in new diagnoses of chronic conditions across England.
Conditions requiring routine tests, like asthma and COPD, saw diagnosis rates fall by 30–50%.
Recovery patterns varied: depression diagnoses declined since 2022, while chronic kidney disease diagnoses have doubled.
Real-time analysis of anonymised health records now enables faster detection of changing disease patterns.
Why this is important: Millions of people in England missed diagnoses for chronic conditions during COVID-19, creating a hidden health burden. However, advances in anonymised medical record analysis now allow researchers to detect these gaps in near real-time, offering healthcare systems a powerful tool to identify problems and respond more quickly.
INFOGRAPHIC
EDUCATION
The McMillan Community is home to the ROOT Approach - a clear, structured system for understanding inflammation, health timelines, and recovery.
We are building a 12-week guided course designed to help you apply ROOT principles to your own health first, and then safely support others through education, insight, and pattern recognition.
This is for those who want understanding — not shortcuts.
MEDICAL NEWS IN BRIEF
NEWS HIGHLIGHTS
🚥 How Our Nasal Passages Defend Against the Common Cold and Help Determine How Sick We Get: Whether you catch a cold depends less on the virus entering your nose and more on how quickly your nasal cells mount a defense. This research suggests that future treatments could focus on boosting your body's natural protective responses rather than attacking the virus directly. [SOURCE]
🚥 High-Dose Inhaled Nitric Oxide Shows Early Promise As a Potential Antimicrobial Therapy: Antibiotic-resistant infections could kill over 10 million people yearly by 2050. Researchers have now shown that high-dose inhaled nitric oxide safely kills dangerous hospital bacteria in lab and animal tests, and appears safe in humans. This opens a promising new avenue for fighting infections when conventional antibiotics fail. [SOURCE]
🚥 The Truth About Detoxes – by a Liver Specialist: Your liver doesn't need rescuing. This article reveals that popular detox products, from charcoal capsules to turmeric supplements, aren't just ineffective but can cause genuine liver damage. The unglamorous truth: moderation, hydration, and consistency protect your liver far better than any January cleanse ever could.
🚥 Dietary Supplement May Protect Against Inflammation-Related Injury and Death by Enhancing Kidney Function: Inflammation often determines whether illness leads to recovery or death. Researchers discovered that methionine, a common dietary amino acid, protects mice from inflammatory damage by enhancing kidney filtration of harmful proteins. This suggests simple nutritional interventions could one day redirect patients away from fatal disease trajectories toward survival. [SOURCE]
🚥 Whole-Food Diet Adherence Means You Really Can Eat Much More and Be Well-Nourished but Still Consume Far Fewer Calories: Our bodies appear hardwired to seek out essential vitamins and minerals, naturally steering us toward nutrient-dense fruits and vegetables. Ultra-processed foods short-circuit this instinct by bundling micronutrients with high calories, eliminating the healthy trade-off that normally guides us toward lower-calorie choices and balanced eating. [SOURCE]
🚥 Five Warning Signs of Diabetes: Nearly 12% of Americans have diabetes, many without knowing it. Because early diabetes often presents no symptoms, waiting until you feel unwell means the disease may already be advanced. Regular screening by age 35, particularly for those with risk factors, enables earlier treatment and prevents serious complications.
BOOK NOOK
Set within a child’s nose, ‘Humming Heroes’ features a family of Lymphocytes led by a wise Mother, brave Father, determined Brother, and heroic Baby, confronting invading microorganisms. The story takes an imaginative turn, when a humming melody combines with the Lymphocytes’ song to repel the invaders and restore inner harmony. |
"Disease X: Are You Prepared?" is your comprehensive guide to navigating the uncertain future of global health. Drawing from experience and the latest scientific insights, this book offers:
|
ADVERTISING
One Simple Scoop For Better Health
The best healthy habits aren't complicated. AG1 Next Gen helps support gut health and fill common nutrient gaps with one daily scoop. It's one easy routine that fits into real life and keeps your health on track all day long. Start your mornings with AG1 and keep momentum on your side.
Fact-based news without bias awaits. Make 1440 your choice today.
Overwhelmed by biased news? Cut through the clutter and get straight facts with your daily 1440 digest. From politics to sports, join millions who start their day informed.








